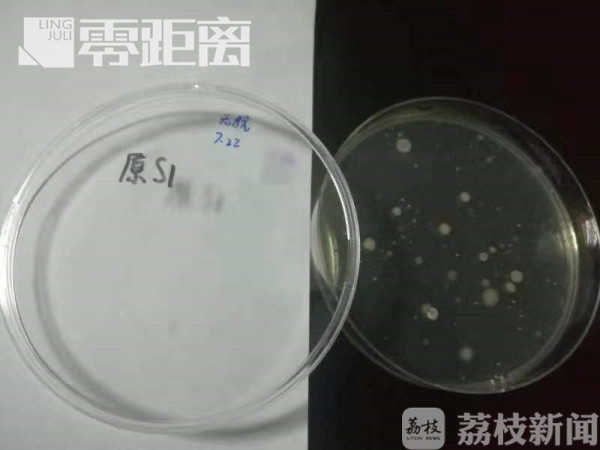

葡萄干、红枣干这些干果类食品,是很多人非常喜爱的日常零食。不过有网友说,干果在制作过程中,会接触环境中的灰尘和微生物,吃之前最好洗一洗,这种说法是对的吗?

吃干果前最好洗一洗?相信这种说法会让很多习惯开袋即食的人感到不解。那么,干果到底干净与否呢?记者从南京的一家大型超市,分别买了两种不同类型、完整包装的葡萄干,以及一袋红枣干和松茸干来做对比。随后,记者来到了南京大学微生物实验室,向大家展示干果在显微镜下的样子。

南京大学医学院研究生姜娜介绍:“我们刚刚在显微镜下观察了白葡萄、红葡萄、红枣和松茸表面的微生物,发现洗之前和洗之后还是有明显的差别,这些干果类的表面有一些黑色的实质性的颗粒,我们怀疑可能是尘土。”

在显微镜下可以清晰地看到,清洗之前的干果比清洗之后的干果表面有着更多的黑色颗粒。这些物质很可能是制作干果过程中,环境中的粉尘灰尘沉积。

为了更直接地证实这些污染物,研究员又对洗之前和洗之后的干果进行取样,放进了细菌培养皿,并且等待了24小时。可以发现,记者购买来的干果上存在细菌,但清洗之后的菌落数明显变少了。
南京大学医学院教授吴稚伟表示:“如果不是控制条件下风干的话,我觉得很自然这些干果会受一些环境因素影响。有良好的工艺过程,有一定的质量控制,有环境受控制,这样可以保证质量和安全。”

专家建议,如果购买的是市面上的散装干果,更容易粘上土和灰尘,食用之前还是清洗一下为好。对于不愿因清洗而牺牲口感的市民来说,也不用过于担心,只要是经过现代化加工、正规生产包装的干果,食品卫生安全往往都是有保障的,开袋即食也没有问题。

中大医院内分泌科主任、营养专家金晖指出,干果最重要的特点是水分少、糖分比较多,它把水分蒸发了以后,剩下更多的是以碳水化合物为主,糖分比较多,所以对一些高危的人群比如说肥胖、糖尿病、高脂、高血压的人来说,还是建议要适当控制。
营养专家也提醒,在选购干果食品时,除了看包装等信息,还要注意它们的高糖属性,像葡萄干的含糖量可以达到80%以上,需要控制血糖的人群,千万不能一吃就收不住了,而要根据自身情况控制进食量。
(来源:《零距离》记者/王华素 编辑/贝茜)







公安备案号:32010202010067
我要说两句